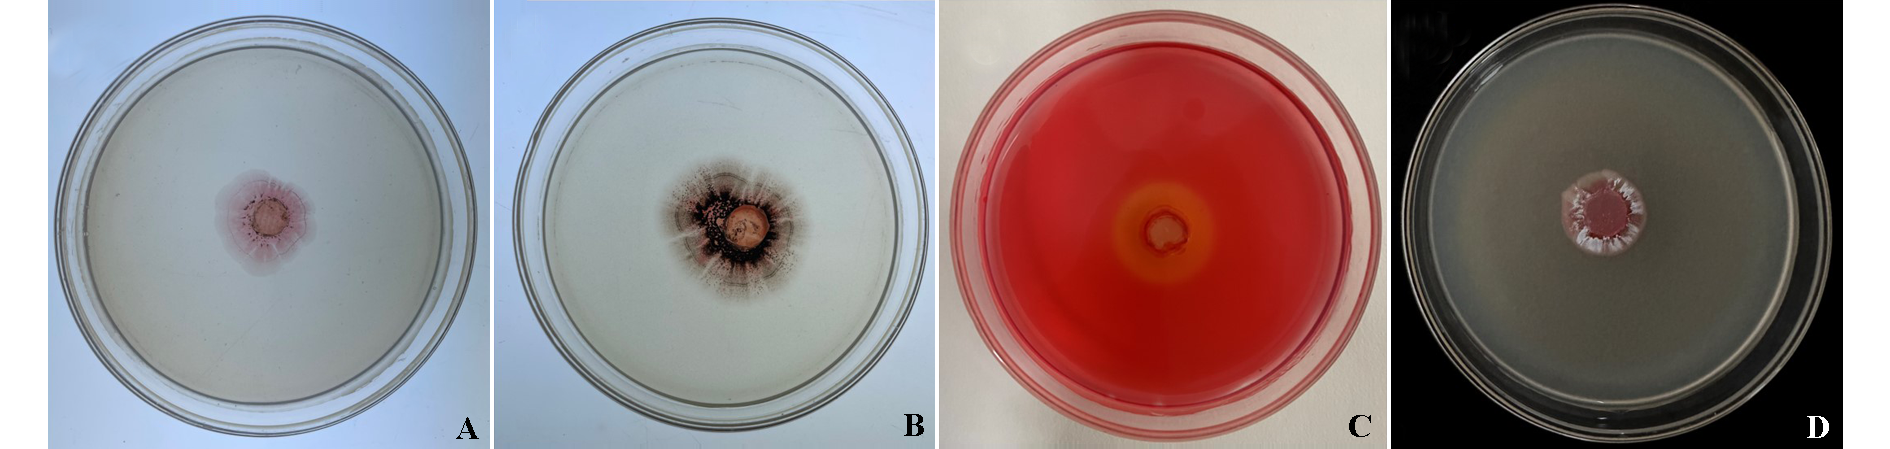

园艺学报 ›› 2024, Vol. 51 ›› Issue (1): 175-189.doi: 10.16420/j.issn.0513-353x.2023-0058
收稿日期:2023-04-23
修回日期:2023-09-19
出版日期:2024-01-25
发布日期:2024-01-16
通讯作者:
基金资助:
LIU Shida, QIU Zelan, LI Xiaogang, ZHONG Jie, ZHU Junzi*( )
)
Received:2023-04-23
Revised:2023-09-19
Published:2024-01-25
Online:2024-01-16
摘要:
通过平板对峙培养法从辣椒根际土壤中筛选到1株对辣椒白绢病菌(Sclerotium rolfsii)具有抑制活性的放线菌株SD-64。利用形态学观察和分子生物学方法对其进行了鉴定,研究其对辣椒白绢病的防效以及对白绢病菌的作用机制,并对菌株SD-64发酵液粗提物进行了提取。结果表明,菌株SD-64对白绢病菌的平板抑制率达到99.27%。基于形态和16S rDNA鉴定SD-64为灰橙链霉菌(Streptomyces griseoaurantiacus)。SD-64能产生黑色素和纤维素酶,其发酵产物可以影响辣椒白绢病菌菌核的产生与萌发,影响菌丝形态,破坏细胞膜的完整性,增加菌丝内活性氧的积累。辣椒离体叶片和活体盆栽防效试验显示SD-64发酵液能明显降低辣椒白绢病的发生。SD-64发酵液粗提物对辣椒白绢病菌的EC50为78.281 μg · mL-1。综上所述,菌株SD-64对辣椒白绢病菌具有的良好防治效果,具有开发应用潜力。
刘仕达, 邱泽澜, 李晓刚, 钟杰, 朱俊子. 辣椒白绢病拮抗放线菌SD-64的鉴定及作用机制研究[J]. 园艺学报, 2024, 51(1): 175-189.
LIU Shida, QIU Zelan, LI Xiaogang, ZHONG Jie, ZHU Junzi. Identification and Mechanism Characterization of Antagonistic Actinomyces SD-64 Against Pepper Southern Blight[J]. Acta Horticulturae Sinica, 2024, 51(1): 175-189.
| 浓度/% Concentration | 菌落直径/cm Colony diameter | 抑菌率/% Inhibition rate |
|---|---|---|
| 0(对照Control) | 5.42 ± 0.07 | — |
| 1 | 3.92 ± 0.34 b | 32.54 ± 0.07 d |
| 2 | 4.52 ± 0.50 a | 19.55 ± 0.11 e |
| 5 | 2.68 ± 0.13 c | 59.24 ± 0.03 c |
| 10 | 1.88 ± 0.12 d | 76.55 ± 0.03 b |
| 20 | 1.17 ± 0.05 e | 92.06 ± 0.01 a |
表1 不同浓度SD-64菌株发酵液对辣椒白绢病菌的抑菌率
Table 1 Inhibition rate of strain SD-64 on Sclerotium rolfsii
| 浓度/% Concentration | 菌落直径/cm Colony diameter | 抑菌率/% Inhibition rate |
|---|---|---|
| 0(对照Control) | 5.42 ± 0.07 | — |
| 1 | 3.92 ± 0.34 b | 32.54 ± 0.07 d |
| 2 | 4.52 ± 0.50 a | 19.55 ± 0.11 e |
| 5 | 2.68 ± 0.13 c | 59.24 ± 0.03 c |
| 10 | 1.88 ± 0.12 d | 76.55 ± 0.03 b |
| 20 | 1.17 ± 0.05 e | 92.06 ± 0.01 a |

图4 菌株SD-64对辣椒白绢病菌菌核质量(A)和萌发率(B)的影响 不同小写字母表示处理间差异显著,P < 0.05。下同。
Fig. 4 Effect of strain SD-64 on Sclerotium rolfsii weight (A) and germination rate (B) Different lowercase letters indicate significant differences between treatments,P < 0.05. The same below.
| 培养基 Medium | 气生菌丝 Aerial mycelium | 基内菌丝 Substrate mycelium | 可溶性色素 Soluble pigment | 生长状况 Growth |
|---|---|---|---|---|
| ISP2 | 白色White | 红色Red | 无 None | +++ |
| ISP3 | 白色White | 白色White | 无None | ++ |
| ISP4 | 白色White | 淡黄色Light yellow | 无None | +++ |
| ISP5 | 淡红色Light red | 淡黄色Light yellow | 无None | + |
| ISP6 | 黄色Yellow | 黄色Yellow | 无None | +++ |
| ISP7 | 白色White | 黄色Yellow | 黄色Yellow | +++ |
表2 菌株SD-64的生长和培养特征
Table 2 Growth and cultural characteristics of strain SD-64
| 培养基 Medium | 气生菌丝 Aerial mycelium | 基内菌丝 Substrate mycelium | 可溶性色素 Soluble pigment | 生长状况 Growth |
|---|---|---|---|---|
| ISP2 | 白色White | 红色Red | 无 None | +++ |
| ISP3 | 白色White | 白色White | 无None | ++ |
| ISP4 | 白色White | 淡黄色Light yellow | 无None | +++ |
| ISP5 | 淡红色Light red | 淡黄色Light yellow | 无None | + |
| ISP6 | 黄色Yellow | 黄色Yellow | 无None | +++ |
| ISP7 | 白色White | 黄色Yellow | 黄色Yellow | +++ |

图6 菌株SD-64对辣椒白绢病菌防效试验 A、B为离体叶片接种;C为活体接种。Ⅰ~ Ⅳ分别为对照、SD-64菌悬液、SD-64发酵液、0.4%噻呋酰胺处理。
Fig. 6 Inoculation experiment of strain SD-64 on Sclerotium rolfsii A and B were in vitro leaves inoculation;C is in vivo inoculation. Ⅰ-Ⅳ were treated with control,SD-64 bacterial suspension,SD-64 fermentation broth and 0.4% Thiafuramide,respectively.
图10 菌株SD-64的产胞外酶能力检测 A:产果胶酶培养基;B:产葡聚糖酶培养基;C:产纤维素酶培养基;D:产几丁质酶培养基。
Fig. 10 Results of extracellular enzyme production of strain SD-64 A:Pectinase production medium;B:Glucanase production medium;C:Cellulase production medium;D:Chitinase production medium.
| 浓度/(μg · mL-1) Concentration | 菌落直径/cm Colony diameter | 抑菌率/% Inhibition rate |
|---|---|---|
| 0(对照Control) | 6.32 ± 0.04 | — |
| 30 | 5.21 ± 0.24 a | 19.99 ± 0.04 f |
| 60 | 4.05 ± 0.38 b | 41.12 ± 0.07 e |
| 90 | 3.47 ± 0.20 c | 51.69 ± 0.04 d |
| 120 | 2.22 ± 0.44 d | 74.34 ± 0.08 c |
| 150 180 | 1.25 ± 0.14 e 0.80 ± 0.00 f | 91.85 ± 0.02 b 100.00 ± 0.00 a |
表3 菌株SD-64发酵液粗提物对辣椒白绢病菌的抑菌率
Table 3 Antibacterial activity of crude extract from fermentation broth of strain SD-64 against Sclerotium rolfsii
| 浓度/(μg · mL-1) Concentration | 菌落直径/cm Colony diameter | 抑菌率/% Inhibition rate |
|---|---|---|
| 0(对照Control) | 6.32 ± 0.04 | — |
| 30 | 5.21 ± 0.24 a | 19.99 ± 0.04 f |
| 60 | 4.05 ± 0.38 b | 41.12 ± 0.07 e |
| 90 | 3.47 ± 0.20 c | 51.69 ± 0.04 d |
| 120 | 2.22 ± 0.44 d | 74.34 ± 0.08 c |
| 150 180 | 1.25 ± 0.14 e 0.80 ± 0.00 f | 91.85 ± 0.02 b 100.00 ± 0.00 a |
| [1] |
|
| [2] |
doi: 10.1094/PDIS-12-19-2673-RE pmid: 33170770 |
| [3] |
|
| [4] |
|
| [5] |
|
|
陈海雁, 陈向东, 俞黎姗. 2020. 黑色素形成机理、生物学功能和应用开发的研究进展. 生物资源, 42 (6):652-659.
|
|
| [6] |
doi: 10.3389/fmars.2021.710200 URL |
| [7] |
|
|
方园, 彭勇政, 廖长贵, 陈路生, 周琦, 黄俭, 阎依超, 王慕媛, 张祎坤, 邹丽芳, 陈功友. 2022. 一株具有防病促生功能的贝莱斯芽孢杆菌SF327. 微生物学报, 62 (10):4071-4088.
|
|
| [8] |
|
|
方中达. 1979. 植病研究方法. 北京: 农业出版社.
|
|
| [9] |
pmid: 6357051 |
| [10] |
|
| [11] |
doi: 10.1007/s12010-020-03328-4 |
| [12] |
doi: 10.1016/j.biocontrol.2003.08.001 URL |
| [13] |
doi: 10.1016/j.micres.2015.11.003 URL |
| [14] |
doi: 10.1016/j.envres.2023.115338 URL |
| [15] |
doi: 10.1128/JB.05053-11 URL |
| [16] |
|
|
李佳佳, 李昭煜, 漆永红, 潘晓梅, 田永强. 2020. 枸杞炭疽病生防菌株筛选、生物功能测定及防治效果. 植物保护学报, 47 (6):1343-1352.
|
|
| [17] |
|
| [18] |
doi: 10.1002/ps.5744 pmid: 31943663 |
| [19] |
|
|
林琪童, 杨丽荣, 夏明聪, 孙润红, 李洪连, 张洁. 2020. 小麦茎基腐病生防菌株YB-161的分离鉴定及防效测. 植物保护学报, 47 (4):939-948.
|
|
| [20] |
|
|
柳惠庆, 高克祥, 史靖. 1995. 楂扦插苗自绢病的研究. 河北林学院学报, 10 (1):54-61.
|
|
| [21] |
|
|
刘均珠, 黄玉婷, 梁丽陈, 陈桂慈, 王琴, 覃拥灵, 何海燕. 2022. 产果胶酶菌株的筛选鉴定及产酶条件初步优化. 饲料研究, 45 (11):71-75.
|
|
| [22] |
|
|
刘衍刚. 2020. 辣椒白绢病的危害症状及综合防治措施. 上海蔬菜,(5):58-59.
|
|
| [23] |
doi: 10.1016/j.postharvbio.2019.01.005 URL |
| [24] |
|
| [25] |
pmid: 10048567 |
| [26] |
pmid: 1612429 |
| [27] |
doi: 10.3389/fmicb.2015.00273 pmid: 25904906 |
| [28] |
doi: 10.1590/S1516-89132015060271 URL |
| [29] |
|
|
秦涵淳, 杨腊英, 李松伟, 谢玉萍, 黄俊生. 2010. 香蕉镰刀菌枯萎病拮抗放线菌的分离筛选及其抑制效果的初步评价. 中国生物防治, 26 (2):174-180.
|
|
| [30] |
|
|
阮宏椿, 石妞妞, 杜宜新, 陈福如. 2021. 水稻稻瘟病拮抗稀有放线菌的筛选及防治效果. 中国生物防治学报, 37 (3):538-546.
doi: 10.16409/j.cnki.2095-039x.2021.02.015 |
|
| [31] |
doi: 10.1094/PDIS-05-16-0645-RE URL |
| [32] |
doi: 10.1094/Phyto-74-730 URL |
| [33] |
doi: 10.1016/j.jneuroim.2023.578200 URL |
| [34] |
doi: 10.1093/molbev/mst197 URL |
| [35] |
pmid: 11566388 |
| [36] |
doi: 10.1007/s11274-020-02941-z |
| [37] |
doi: 10.1038/s41579-020-0379-y pmid: 32483324 |
| [38] |
doi: 10.1016/j.postharvbio.2020.111456 URL |
| [39] |
doi: 10.1007/s002030100345 pmid: 11702082 |
| [40] |
|
|
魏林. 2022. 辣椒白绢病为害特点及其综合防治. 湖南农业,(8):13.
|
|
| [41] |
doi: 10.1016/j.pestbp.2021.104834 pmid: 33993959 |
| [42] |
|
|
徐月华. 2009. 辣椒白绢病的发生影响因子调查分析及综合防治技术探讨. 中国植保导刊, 29 (6):25-26.
|
|
| [43] |
doi: S0009-8981(20)30314-4 pmid: 32628921 |
| [44] |
|
|
杨学辉, 袁洁, 谢海呈. 2004. 贵州省辣椒主要病害及防治技术. 贵州农业科学, 32 (2):54-55.
|
| [1] | 蔡泽彦, 张明星, 周池, 陶禹, 杨莎, 李鑫, 李雪峰. 辣椒疫病不同抗性品种内生微生物群落多样性、结构及功能分析[J]. 园艺学报, 2025, 52(2): 322-336. |
| [2] | 杨文清, 王嘉荟, 徐秉良, 李惠霞, 梁巧兰, 杨顺义, 牛二波. 甘肃定西地区辣椒病毒病鉴定及BWYV遗传变异分析[J]. 园艺学报, 2025, 52(2): 491-502. |
| [3] | 黄勋, 刘霞, 邓琳梅, 王兴国, 徐亚锦, 杨艳丽. 马铃薯疮痂病生防菌1X1Y的鉴定及其生防促生特性研究[J]. 园艺学报, 2025, 52(1): 229-246. |
| [4] | 邹学校, 杨莎, 戴雄泽, 胡博文, 徐昊, 朱凡, 裴宋雨, 远方. 中国辣椒产业快速发展40年回顾与展望[J]. 园艺学报, 2025, 52(1): 247-258. |
| [5] | 刘宇, 张敏, 谈杰, 黄树苹, 张洪源, 王本启, 王俊良, 陈惠兰, 陈霞. 茄科蔬菜糖苷生物碱及其生物活性研究进展[J]. 园艺学报, 2024, 51(9): 2207-2218. |
| [6] | 李怡斐, 杨小苗, 王春萍, 段敏杰, 黄启中, 黄任中, 张世才. 加工型辣椒新品种‘艳椒465’[J]. 园艺学报, 2024, 51(9): 2223-2224. |
| [7] | 段敏杰, 李怡斐, 王春萍, 杨小苗, 黄任中, 黄启中, 张世才. 辣椒果实类胡萝卜素调控因子转录组和靶向代谢组分析[J]. 园艺学报, 2024, 51(8): 1773-1791. |
| [8] | 石凤岩, 王治丹, 张曦, 王秀雪, 邹春蕾. 辣椒疫病抗性机制研究进展[J]. 园艺学报, 2024, 51(7): 1665-1682. |
| [9] | 张茹, 陈灵芝, 王兰兰. 辣椒新品种‘陇椒13号’[J]. 园艺学报, 2024, 51(7): 1709-1710. |
| [10] | 覃艮红, 袁洪波, 王卓妮, 史冰柯, 范洋洋, 王丽, 张猛, 涂洪涛, 徐超, 侯珲. 蜡样芽孢杆菌挥发物对苹果轮纹病菌的拮抗活性[J]. 园艺学报, 2024, 51(6): 1403-1412. |
| [11] | 王青, 胡燕, 陈姗, 陆景伟, 郑阳, 陶伟林, 孙现超, 周娜, 陈国康. 绛红褐链霉菌CC2-6抑制大白菜根肿病的效果及机制分析[J]. 园艺学报, 2024, 51(5): 1137-1150. |
| [12] | 韩琴, 高惠惠, 马香, 苏建宇, 徐春燕. 枸杞根际根腐病拮抗细菌的筛选及其防效检测[J]. 园艺学报, 2024, 51(5): 1162-1172. |
| [13] | 郭瑞, 陈高, 赵慧霞, 乾义柯, 兰红, 万何平, 陈禅友. 紫色辣椒新品种‘江大紫椒1号’[J]. 园艺学报, 2024, 51(5): 1175-1176. |
| [14] | 侯雪, 王姣姣, 张雯雯, 赵建龙, 茆振川. 辣椒乙烯反应抑制因子Cacl-6468的克隆及其抗根结线虫作用分析[J]. 园艺学报, 2024, 51(4): 761-772. |
| [15] | 强然, 张岱, 杨喆, 陈明玥, 赵景, 朱杰华. 解淀粉芽胞杆菌L19对马铃薯枯萎病菌的抑制及植株的促生作用[J]. 园艺学报, 2024, 51(4): 875-892. |
| 阅读次数 | ||||||
|
全文 |
|
|||||
|
摘要 |
|
|||||
版权所有 © 2012 《园艺学报》编辑部 京ICP备10030308号-2 国际联网备案号 11010802023439
编辑部地址: 北京市海淀区中关村南大街12号中国农业科学院蔬菜花卉研究所 邮编: 100081
电话: 010-82109523 E-Mail: yuanyixuebao@126.com
技术支持:北京玛格泰克科技发展有限公司